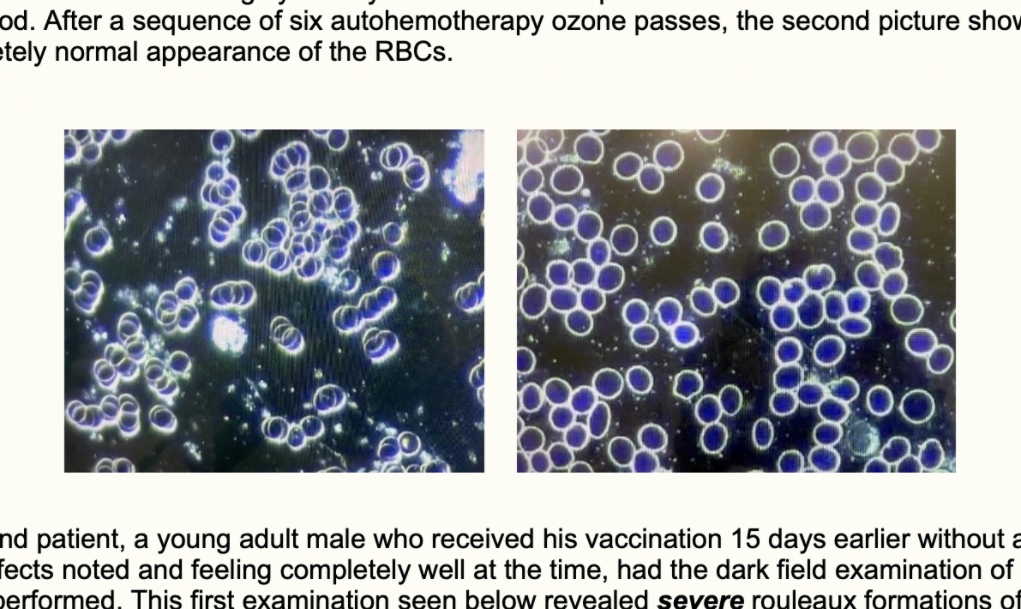

V roce 1930 vynalezl Wilhelm Reich způsob, jak během několika patnáctiminutových sezení vyléčit rakovinu, srdeční choroby, artritidu a tisíce dalších onemocnění. (Foto Flickr)FDA Wilhelmovy vynálezy zakázala a odsoudila ho do vězení, kde v roce 1957 zemřel.Wilhelm Reich vyvinul zařízení s kovovým obložením nazvané Orgonový akumulátor, protože věřil, že krabice zachycuje orgonovou energii, kterou může využít …
Štítek: léčba
Jedním z největších dosud ohledně „vakcín“ proti covid-19 zaznamenaným problémem je fakt, že některým lidem způsobují těžké krevní sraženiny a ucpání cév. (Foto: Thomas E. Levy, MD, JD)Dobrou zprávou ale je, že existuje způsob, jak s tímto kardiovaskulárním rizikem bojovat pomocí ozónové terapie.Nedávno vydal Dr. Thomas E. Levy, M.D., JD. v Orthomolecular Medicine News Service (OMNS) vysvětlení, jak …
Lékařka Etela Janeková léčila svých 188 pacientů ivermektinem, 67 z nich mělo těžký průběh, a proto byl k léčbě přidán vitamin C, D a nízkomolekulární heparin. (Foto: Facebook/TA3) Ani jeden z jejích pacientů neskončil na plicní ventilaci. Praktická lékařka pro dospělé, doktorka Etela Janeková, hovoří o tom, jak přesně dávkovat Ivermektin, pokud ho již někdo …
Slovenský občan, který se momentálně nachází v La Paz (Bolívie, Jižní Amerika) informuje ve svých facebookových statusech o péči státu vůči pacientům s onemocněním Covid-19. (Foto: Facebook)La Paz je město, kde je relativně zima a sucho (ideálně podnebí pro šíření Covid-19). Má přes 800 000 obyvatel, hustě osídlené. Přestože je zde vše otevřené (dnes jsem …
Málo známá rostlina, která má skutečně bizarní jméno, se v poslední době objevuje na titulních stránkách jako ničitel rakoviny. Tato rostlina obsahuje sloučeninu, která odstraňuje nádor u myší s rakovinou slinivky. (Foto: Wikimedia)Je známá jako réva boha hromu. Ve skutečnosti je tato rostlina zařazena v čínské medicíně a používá se už věky na léčení několika …
Enjoy Unlimited Digital Access
Already a subscriber? Log in